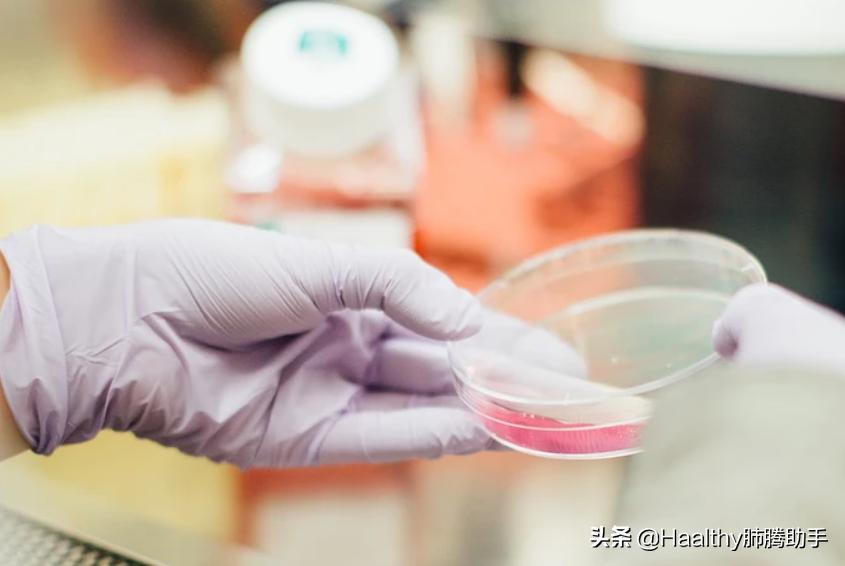
十大注意事项让肺癌患者活得更久,肺癌少遭罪又有效的治疗方法

很多早期癌症都是通过体检发现的,体检对我们发现癌症来说至关重要。
有多重要?不仅省钱还救命。
经体检发现的早期肺癌接受手术的患者不仅生存率高,医疗花费还比晚期患者要低六成以上。这个晚期肺癌治疗的费用不是开玩笑,比如那些PD-1神药,一年药费就得十几二十万,5年生存率15%左右。肺腾 助手平台针对上千肺癌患者的一次调研显示,晚期肺癌患者一年药物花费加上各种检查和交通住宿费用,平均接近30万。而早期肺癌外科手术加术后辅助化疗,有医保报销价格低得多,患者一般仅需自付几万块,5年生存率达70-90%。
但是对于肺癌,常规体检有着很大的弊端,因为常规体检项目里胸部检查通常是X线胸片等。这些检查对于发现肺部结节有很大的局限性,容易遗漏肺结节的病灶。
近日在肺腾病友群内也有病友提到自己的亲属公司组织体检,没有低剂量螺旋CT项目筛查肺癌,在群里征询大家的意见,为了安心,需不需要再花钱检测下呢?
筛查肺癌,能做当前主流推荐的低剂量螺旋CT当然好,但是往往体检套餐有时不包含。那每年做的这些影像学检查,体检套餐里杂七杂八的各种项目,对筛查肺癌的作用到底有多大,需不需要追加一个低剂量螺旋CT?一起来看看吧。
| LDCT筛查方便快捷,辐射低,价钱也合理
在低剂量螺旋CT被权威机构认可前,肺癌常规筛查手段包括 X 线胸片检查、痰细胞学检查以及血清肿瘤标记物检测等,但这些筛查方式受敏感度及特异度限制,效果都不理想。要做到早期发现肺癌,现在主流推荐的就是低剂量螺旋CT(LDCT)。
它的辐射剂量比常规CT低了90%,接受一次低剂量螺旋CT的辐射量相当于 15 次 X 光胸片检查、乘坐飞机 300 小时、人体半年受到的自然辐射,而且随着技术发展,辐射剂量有进一步减少的趋势。

一次低剂量螺旋CT的辐射量等同与乘坐飞机 300 小时 图片来源:pixabay
而且LDCT辐射低,精度却不低。其对肺部筛查有助于发现早期肺癌,特别是周围型非小细胞肺癌,其诊出率约为X线胸片的10倍,可发现肺部1mm的结节,是早期肺癌诊断的“金标准”。欧洲大型肺癌筛查研究 NELSON中接受LDCT筛查确诊肺癌的患者50%为Ia期,即是没有转移的早期,这些患者只需要接受外科手术,无需化疗,预后良好,5年生存率80%以上,而对照组无筛查却确诊肺癌的患者接近50%为IV期,即有远处转移的晚期,这些患者5年生存率显著低于Ia期患者,5年生存率只有5-15%。
LDCT检查本身费用也不高,也不需要吃药,也不需要打针,只需你在进行胸部扫描时必须屏住呼吸至少 6 秒钟,就可以完成这项筛查,简单高效。
如果LDCT筛查结果发现肺部结节阳性怎么办?首先,不要太过紧张。因为,任何筛查手段都存在把没患病的人报告为“阳性”——即“假阳性”的情况。灵敏度越高的检查手段,假阳性率通常也会比较高。一项国外的大型荟萃分析结果显示对无症状高危人群进行LDCT 筛查的假阳性率为 23.1%。因此,当 LDCT 提示恶性结节可能的时候,应立刻到专科就诊,医生可能要求你另外做一些检查再结合各项结果综合评估判断。
如果没有显示阳性,也别太放松。因为有些病理类型的肺癌长得比较快。例如,小细胞肺癌最快只要一个月左右,癌细胞数量就会翻一倍。因此,如果LDCT筛查结果没发现肺部结节,也要保持健康的生活方式并戒烟,这样才能让肺癌真正远离你。
| 常规CT
放射剂量是低剂量螺旋CT的5倍。为了解决辐射问题,低剂量螺旋CT应运而生。但在选择降低剂量的同时,图像的清晰度也有所下降,所以它可以发现问题,但有时候部分病灶的进一步确诊还是需要再做检测。
这就解释了有少数人做了CT,发现了问题还会被要求进一步做其他类型的CT检查,因为CT检查也有多种,不同检查之间有相互补充的作用。
| 体检最常见的项目——X线胸片
在国内的大多数体检里,胸片X线检查可以说是最为常见。因为价格便宜,辐射也相对较弱,非常适合年轻、相对身体比较健康的人群,每年做一次常规的体检。

图片来源:pixabay
但是X线胸片也有很一个不可忽视的问题——较小的肺部病灶很难发现,肺部的小结节或微小结节很容易被肋骨、膈肌、纵隔组织器官等遮挡,容易遗漏了大部分直径小于2cm的病灶。据统计,约有22%-63%的肺癌病灶容易被漏诊。有些患者在临床确诊肺癌时就已经是中/晚期,失去了外科手术根治的最佳时机。
所以如果是肺癌高危人群,体检做了X线胸片,并不保险!不推荐将X线胸片作为肺癌筛查工具,体检照胸片来排查肺癌也是无效的。
| 简便有效的痰细胞学检测
痰液细胞学检查是肺癌诊断中较为便捷、经济的方法而且因为患者易接受、特异性较高等优势而广泛应用于肺癌的筛查。
这种检查方式可以筛查脱落的癌细胞,鳞癌阳性率较其他类型为高,但就算痰细胞学检查阴性,也不能去完全排除肺癌的可能性,所以,在低剂量螺旋CT出现之后,也不再被推荐用来筛查,而是用于辅助诊断。
图片来源:pixabay
因为无痛简单价格便宜,痰细胞学检测可以反复操作,送检次数越多,阳性率越高,如果痰液内找到癌细胞应高度怀疑肺癌的可能。在体检中发现结果呈现阳性,需要配合医生进一步确诊检查。
| 血清肿瘤标记物检测
肿瘤标记物血清水平与癌症的发生、发展、消退、复发等有关系。当癌症发生发展时,肿瘤标记物的血清水平可能会出现明显异常。因为肿瘤标记物检查方法简单,抽血就行,在常规体检中常常用来筛查癌症。
那是不是检查发现肿瘤标志物高,就说明得了癌症呢?如果是轻微升高,不必紧张。人体一些正常组织或良性肿瘤以及炎症反应,也可能使肿瘤标记轻度升高。
需要注意的是以下几种类型的升高:1.单次检查“肿瘤标志物”升高特别明显,可能是正常值几倍;2.反复检查几次,数值持续升高;3.家族中有肿瘤患者,检查相应的肿瘤标志物有升高。这三种结果,提示可能需要进一步通过B超、CT等手段检查,必要时须通过病理检查才能明确诊断。

图片来源:pixabay
复旦大学附属中山医院呼吸科与危重症医学科主任宋元林教授指出,“肿瘤标志物异常并不代表就是患癌,肿瘤标志物不异常也不代表没有癌。因为某些标志物的特异性和敏感度有限,假阳性和漏检情况都是存在的。所以作为筛查,不合适。肺癌标志物可用于辅助诊断、复发转移及治疗的随访”。
| 体检中的基因检测,筛查肺癌靠不靠谱?
在市面上,还有一些听起来就很“高大上”的体检项目,例如基因检测。
大家熟悉的基因检测分两种,一种目前主要应用于指导肺癌的靶向治疗,还有一种应用于体检,用来筛查癌症的高危人群。

图片来源:pixabay
癌症的遗传性或家族性已经得到现代医学的证实,某些癌症里也已经明确发现了所携带的患癌基因,但这仅仅只占一小部分,对于肺癌来说,虽然也有家族倾向,但还未发现确切特异性的突变基因携带。所以基因检测用于筛查,并不合适。
因为针对肺癌目前并没有行之有效的“预防”药物,如果基因检测体检告知体检者存在着潜在的健康风险,能给大家的提示就是早一步注重身体的健康管理,在往后的体检中加强体检项目的针对性。
结语
市面上体检套餐里的癌症筛查项目,针对性都比较弱,如果是肺癌高危人群,还是建议一年一次低剂量螺旋CT。
留言或私信关键词“入群”,与肺癌患者/患者家属/专业医学顾问交流,或咨询临床入组相关信息。